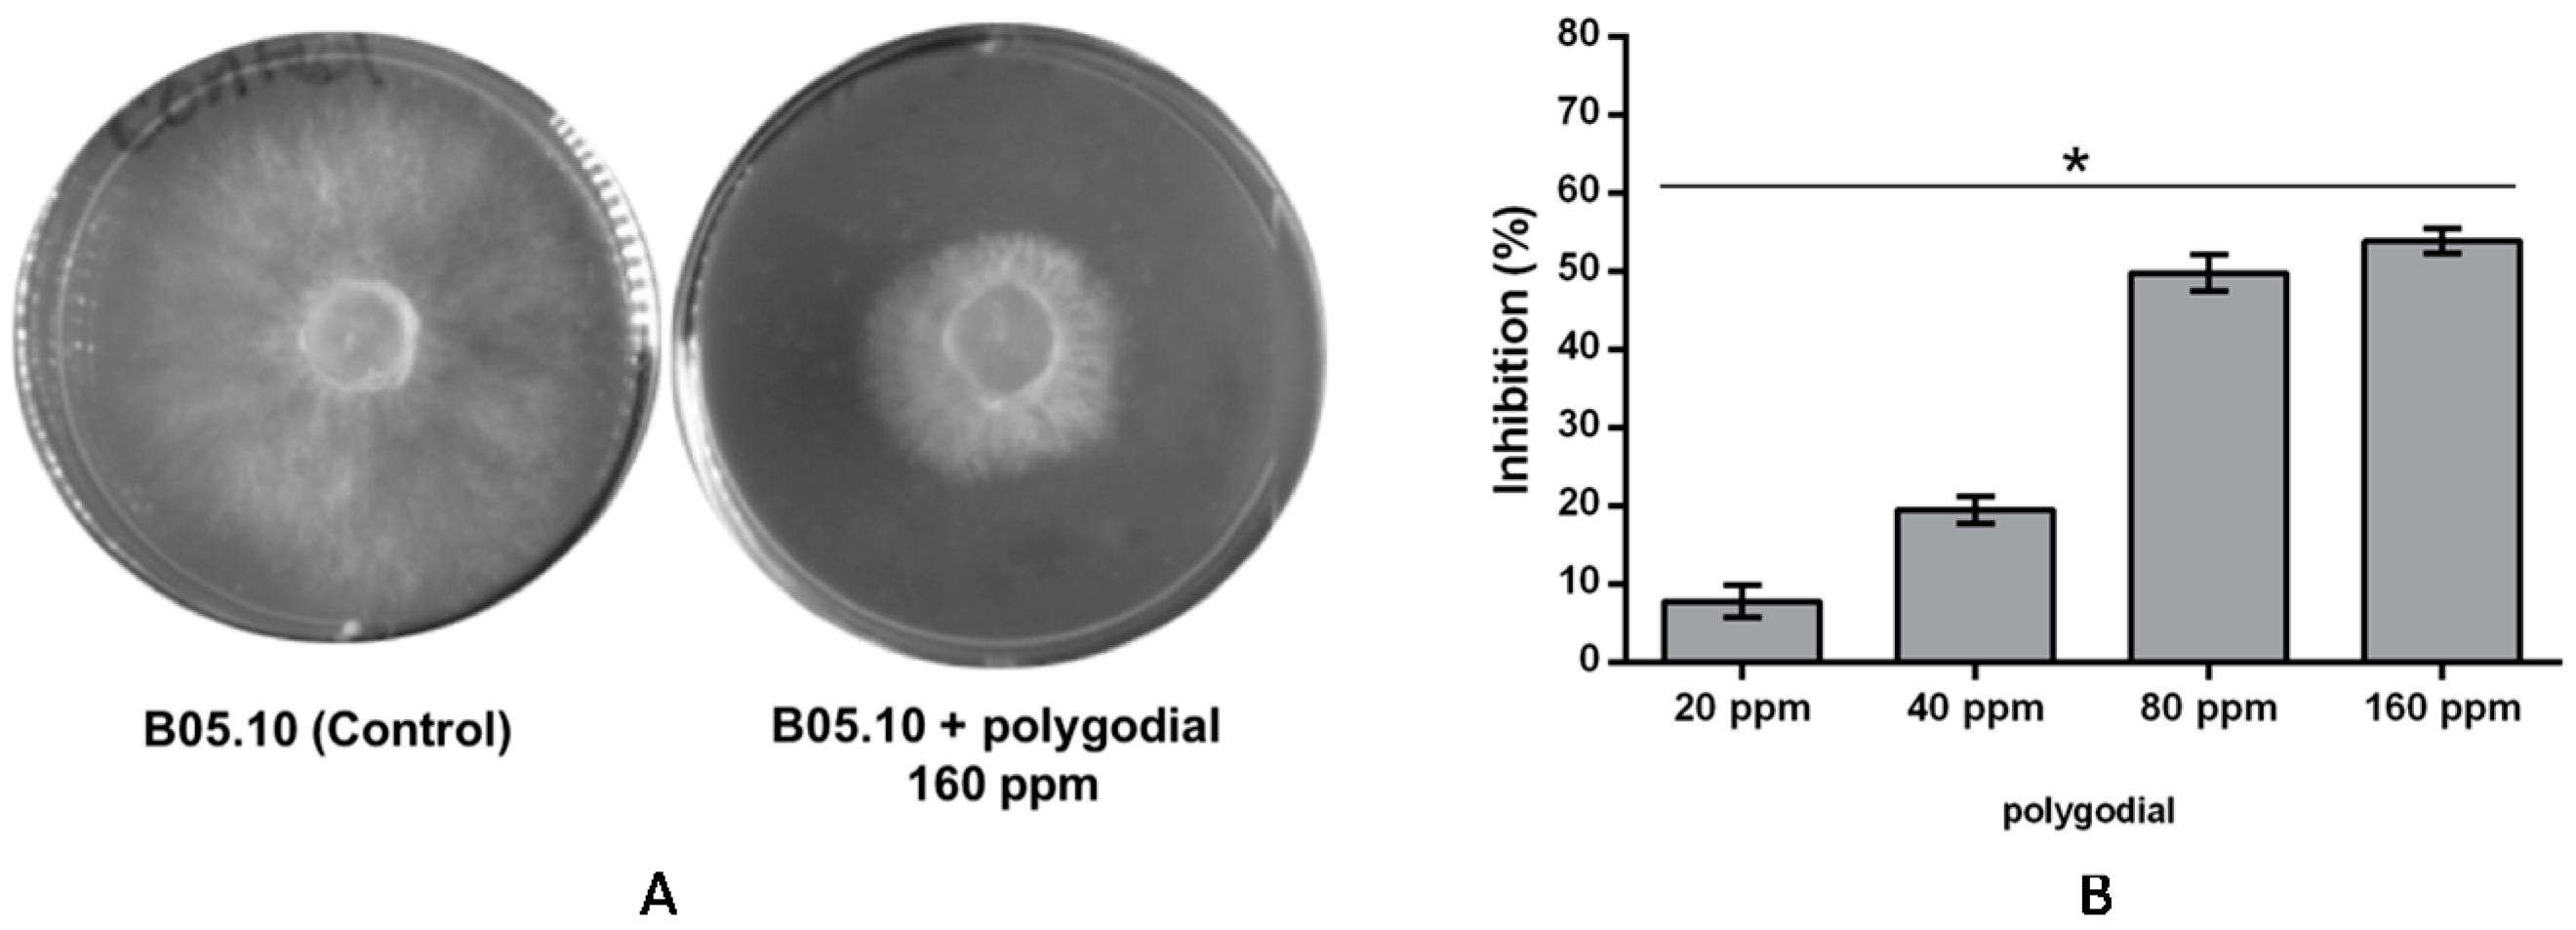
Ijms 18 02251 g002

Antifungal Effect of Polygodial on Botrytis cinerea, a Fungal Pathogen Affecting Table Grapes
Abstract
:1. Introduction
2. Results
2.1. Evaluation of Antifungal Activity of Polygodial on Botrytis cinerea
2.2. Effect of Polygodial on Growth of Isolates of B. cinerea with Different Degrees of Sensitivity to Fungicides Commercially Used
2.3. Effect of Polygodial on Germination of B. cinerea
2.4. Mode of Action of Polygodial on Botrytis cinerea
3. Discussion
4. Materials and Methods
4.1. Chemistry
Extraction and Purification of Polygodial from D. Winteri
4.2. Biological
4.2.1. Fungal Isolate and Culture Conditions
4.2.2. Effect of Polygodial on Mycelial Growth of B. cinerea in Solid Media
4.2.3. Effect of Polygodial on Germination of B. cinerea Conidia
4.3. Mode of Action of Polygodial on B. cinerea
4.3.1. Determination of Membrane Integrity of B. cinerea
4.3.2. Production of Reactive Oxygen Species
4.3.3. Real-Time PCR and Gene Expression
5. Conclusions
Supplementary Materials
Acknowledgments
Author Contributions
Conflicts of Interest
References
- Fillinger, S.; Elad, Y. Botrytis—The Fungus, the Pathogen and Its Management in Agricultural Systems; Springer: Cham, Switzerland, 2015. [Google Scholar]
- Leroux, P.; Fritz, R.; Debieu, D.; Albertini, C.; Lanen, C.; Bach, J.; Gredt, M.; Chapeland, F. Mechanisms of resistance to fungicides in field strains of Botrytis cinerea. Pest Manag. Sci. 2002, 58, 876–888. [Google Scholar] [CrossRef] [PubMed]
- Latorre, B.A.; Torres, R. Prevalence of isolates of Botrytis cinerea resistant to multiple fungicides in Chilean vineyards. Crop Prot. 2012, 40, 49–52. [Google Scholar] [CrossRef]
- Esterio, M.; Auger, J.; Ramos, C.; García, H. First Report of Fenhexamid Resistant Isolates of Botrytis cinerea on Grapevine in Chile. Plant Dis. 2007, 91, 768. [Google Scholar] [CrossRef]
- Esterio, M.; Ramos, C.; Walker, A.S.; Fillinger, S.; Leroux, P.; Auger, J. Phenotypic and genetic characterization of Chilean isolates of Botrytis cinerea with different levels of sensitivity to fenhexamid. Phytopathol. Mediterr. 2011, 50, 414–420. [Google Scholar]
- Vengurlekar, S.; Sharma, R.; Trivedi, P. Efficacy of some natural compounds as antifungal agents. Pharmacogn. Rev. 2012, 6, 91–99. [Google Scholar] [CrossRef] [PubMed]
- Barnes, C.S.; Loder, J.W. The Structure of Polygodial: A New Sesquiterpene Dialdehyde from Polygonum hydropiper L. Aust. J. Chem. 1962, 15, 322–327. [Google Scholar] [CrossRef]
- Kubo, I.; Lee, Y.; Pettei, M.; Pilkiewicz, F.; Nakanishi, K. Potent Army worm antifeedants from the east African Warburgia Plants. J. Chem. Soc. Chem. Commun. 1976, 1013–1014. [Google Scholar] [CrossRef]
- Taniguchi, M.; Chapya, A.; Kubo, I.; Nakanishi, K. Screening of East African Plants for Antimicrobial Activity. I. Chem. Pharm. Bull. 1978, 26, 2910–2913. [Google Scholar] [CrossRef]
- McCallion, R.F.; Cole, A.L.J.; Walker, J.R.L.; Blunt, J.W.; Munro, M.H.G. Antibiotic substances from New Zealand plants. Planta Med. 1982, 44, 134–138. [Google Scholar] [CrossRef] [PubMed]
- Cechinel Filho, V.; Schlemper, V.; Santos, A.R.S.; Pinheiro, T.R.; Yunes, R.A.; Mendes, G.L.; Calixto, J.B.; Delle Monache, F. Isolation and identification of active compounds from Drimys winteri barks. J. Ethnopharmacol. 1998, 62, 223–227. [Google Scholar] [CrossRef]
- Kubo, I.; Fujita, K.; Lee, S.H. Antifungal mechanism of polygodial. J. Agric. Food Chem. 2001, 49, 1607–1611. [Google Scholar] [CrossRef] [PubMed]
- Anke, H.; Sterner, O. Comparison of the Antimicrobial and Cytotoxic Activities of Twenty Unsaturated Sesquiterpene Dialdehydes from Plants and Mushrooms. Planta Med. 1991, 57, 344–346. [Google Scholar] [CrossRef] [PubMed]
- Lee, S.H.; Lee, J.R.; Lunde, C.S.; Kubo, I. In vitro antifungal susceptibilities of Candida albicans and other fungal pathogens to polygodial, a sesquiterpene dialdehyde. Planta Med. 1999, 65, 204–208. [Google Scholar] [CrossRef] [PubMed]
- Taniguchi, M.; Yano, Y.; Tada, E.; Ikenishi, K.; Oi, S.; Haraguchi, H.; Hashimoto, K.; Kubo, I. Mode of Action of Polygodial, an Antifungal Sesquiterpene Dialdehyde. Agric. Biol. Chem. 1988, 52, 1409–1414. [Google Scholar]
- Kubo, I.; Taniguchi, M. Polygodial, an Antifungal Potentiator. J. Nat. Prod. 1988, 51, 22–29. [Google Scholar] [CrossRef] [PubMed]
- Taniguchi, M.; Adachi, T.; Oi, S.; Kimura, A.; Katsumura, S.; Isoe, S.; Kubo, I. Structure–activity relationship of the Warburgia sesquiterpene dialdehydes. Agric. Biol. Chem. 1984, 48, 73–78. [Google Scholar] [CrossRef]
- Derita, M.; Montenegro, I.; Garibotto, F.; Enriz, R.D.; Fritis, M.C.; Zacchino, S.A. Structural requirements for the antifungal activities of natural drimane sesquiterpenes and analogues, supported by conformational and electronic studies. Molecules 2013, 18, 2029–2051. [Google Scholar] [CrossRef] [PubMed]
- Robles-Kelly, C.; Rubio, J.; Thomas, M.; Sedán, C.; Martínez, R.; Olea, A.F.; Carrasco, H.; Taborga, L.; Silva-Moreno, E. Effect of drimenol and synthetic derivatives on growth and germination of Botrytis cinerea: Evaluation of possible mechanism of action. Pestic. Biochem. Physiol. 2017, 141, 50–56. [Google Scholar] [CrossRef] [PubMed]
- Aguayo, C.; Riquelme, J.; Valenzuela, P.; Hahn, M.; Silva Moreno, E. Bchex virulence gene of Botrytis cinerea: Characterization and functional analysis. J. Gen. Plant Pathol. 2011, 77, 230–238. [Google Scholar] [CrossRef]
- Cotoras, M.; Folch, C.; Mendoza, L. Characterization of the Antifungal Activity on Botrytis cinerea of the Natural Diterpenoids Kaurenoic Acid and 3β-Hydroxy-kaurenoic Acid. J. Agric. Food Chem. 2004, 52, 2821–2826. [Google Scholar] [CrossRef] [PubMed]
- Grayer, R.J.; Harborne, J.B. A survey of antifungal compounds from higher plants, 1982–1993. Phytochemistry 1994, 37, 19–42. [Google Scholar] [CrossRef]
- Silva, E.; Valdés, J.; Holmes, D.; Shmaryahu, A.; Valenzuela, P.D.T. Generation and analysis of expressed sequence tags from Botrytis cinerea. Biol. Res. 2006, 39, 367–376. [Google Scholar] [CrossRef] [PubMed]
- Livak, K.J.; Schmittgen, T.D. Analysis of relative gene expression data using real-time quantitative PCR and the 2−∆∆Ct) method. Methods 2001, 25, 402–408. [Google Scholar] [CrossRef] [PubMed]

| Isolate | Host | Resistance |
|---|---|---|
| B05.10 | Grape | none |
| PN2 | Cherry | Fenhexamid, Iprodione, Pyrimethanil, and Boscalid |
| 7AC | Pear | Fenhexamid |
© 2017 by the authors. Licensee MDPI, Basel, Switzerland. This article is an open access article distributed under the terms and conditions of the Creative Commons Attribution (CC BY) license (http://creativecommons.org/licenses/by/4.0/).
Share and Cite
Carrasco, H.; Robles-Kelly, C.; Rubio, J.; Olea, A.F.; Martínez, R.; Silva-Moreno, E. Antifungal Effect of Polygodial on Botrytis cinerea, a Fungal Pathogen Affecting Table Grapes. Int. J. Mol. Sci. 2017, 18, 2251. https://doi.org/10.3390/ijms18112251
Carrasco H, Robles-Kelly C, Rubio J, Olea AF, Martínez R, Silva-Moreno E. Antifungal Effect of Polygodial on Botrytis cinerea, a Fungal Pathogen Affecting Table Grapes. International Journal of Molecular Sciences. 2017; 18(11):2251. https://doi.org/10.3390/ijms18112251
Chicago/Turabian StyleCarrasco, Héctor, Christian Robles-Kelly, Julia Rubio, Andrés F. Olea, Rolando Martínez, and Evelyn Silva-Moreno. 2017. "Antifungal Effect of Polygodial on Botrytis cinerea, a Fungal Pathogen Affecting Table Grapes" International Journal of Molecular Sciences 18, no. 11: 2251. https://doi.org/10.3390/ijms18112251
APA StyleCarrasco, H., Robles-Kelly, C., Rubio, J., Olea, A. F., Martínez, R., & Silva-Moreno, E. (2017). Antifungal Effect of Polygodial on Botrytis cinerea, a Fungal Pathogen Affecting Table Grapes. International Journal of Molecular Sciences, 18(11), 2251. https://doi.org/10.3390/ijms18112251





